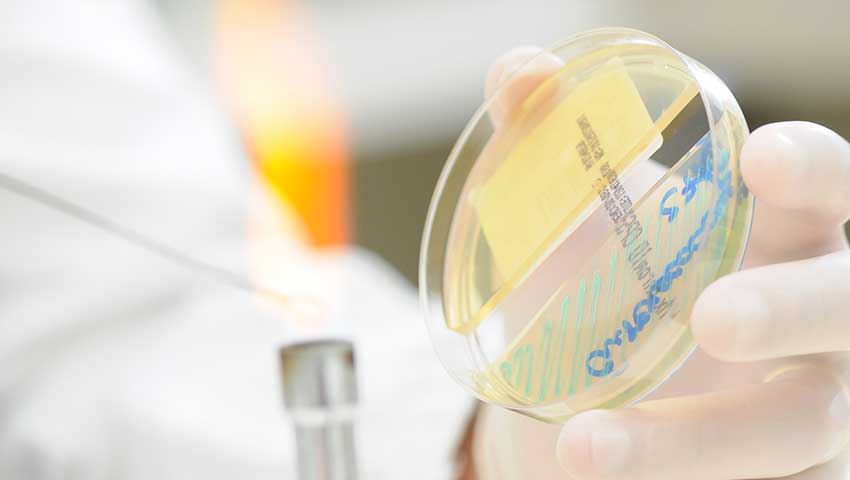

Empresa

O primeiro banco de sangue de Rio Preto foi criado em 1951, na Santa Casa de Rio Preto, pelo clínico geral João Tajara, que sentindo a necessidade do controle sanitário do sangue colhido, montou para esse fim, um pequeno laboratório anexo ao serviço.
Concebido apenas para triagem sorológica de doadores de sangue, o laboratório evoluiu; em 1967 foram implantados os setores de hematologia e de bioquímica de sangue, pelo Dr. José Tajara. O pequeno laboratório abriu então suas portas ao público, com o nome de Laboratório de Hematologia Dr. José Tajara, firmando-se definitivamente.
Numa segunda ampliação (em 1977) além da mudança do nome (para laboratório Tajara Ltda), criaram-se os setores de parasitologia, microbiologia, bioquímica de urina e de genética. A adoção de um sistema de controle de qualidade externo, pela Sociedade Brasileira de Patologia Clínica, veio adicionar ao controle maior segurança nos resultados. Com o crescimento e o aumento do grau de complexidade operacional, decidiu-se em meados da década de 80, pela informatização do laboratório.
Depois de várias tentativas de aquisição de um sistema computacional aceitável, optou-se pelo desenvolvimento de um sistema próprio (um software gerencial total), implantado em 1991.
O Laboratório Tajara, conta atualmente com uma Unidade matriz denominada Unidade Dr. José Tajara e com quatro postos de coleta, em diversos pontos de Rio Preto, interligados a matriz via Shift Lis.
A unidade Dr. José Tajara foi inaugurada em 13/01/2012, sendo sede própria, e na qual está localizada toda a sua área técnica, administrativa e coleta.
Em relação à pessoal, conta com 114 profissionais, sendo 2 médicos, 3 bioquímicos, 6 biomédicos e 5 biólogos.
Modernos aparelhos automatizados integram a área instrumental, entre eles o Vitros 5600 (química seca), que não utiliza reativos diluídos em água no laboratório, praticamente eliminando a possibilidade de erro técnico.
Entre as seções técnicas do Laboratório estão as de Hematologia, Bioquímica, Microbiologia, Sorologia, Hormônios e Parasitologia.
Missão, Visão, Valores e Política da Qualidade
Missão: Realizar exames laboratoriais, com respeito, ética e dignidade aos clientes, auxiliando o médico em seu diagnóstico clínico, por meio de laudos com qualidade.
Visão: Em conjunto com a equipe, expandir a rede de atendimentos na cidade e regiões adjacentes, com prestação de serviços laboratoriais com qualidade, mantendo condições dignas e respeitosas aos nossos clientes, respeitando nossa tradição e referência.
Valores: Integridade, Excelência, Foco no cliente e respeito nos relacionamentos.
Política da Qualidade: Fornecer laudos/ Produtos de Qualidade com confiabilidade, que atendam às necessidades e expectativas de nossos clientes, por meio da busca incessante da melhoria da qualidade dos serviços.